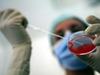
Итальянцев, которые воспользовались услугам суррогатной матери в Украине, оправд

Ему 57 лет, ей 44 года: их ребенок родился пять лет назад в Киеве. Адвокат пары: "Закон неясен, поэтому воспользоваться услугами суррогатной матери не является преступлением".
Итальянскую пару, возпользовавшуюся услугами суррогатной матери в Украине, оправдали в суде Болоньи из-за отсутствия состава преступления. Родители, на которых иск в суд подало итальянское посольство в Киеве, проживают в провинции Болоньи. Отцу ребенку 57, матери - 44 года, их ребенок родился в 2012 году в Киеве, где закон допускает практику суррогатного материнства. Ребенка родила украинка, с которой пара подписала договор в феврале 2010 года.
Посольство Италии в Киеве подало иск на пару по факту нарушения статьи «закона 40», который наказывает тех, кто прибегает к услугам суррогатных матерей в Италии.
Адвокат пары подчеркнул в своей речи отсутствие ясности в уголовном кодексе Италии и отметил, в частности, что в последнее время различных законопроекты были поданы в Кабмин, чтобы изменить норму и дать возможность итальянцам без последующих проблем с законом обращаться к суррогатным матерям.
© 2017 «Италия по-русски»

Re: Итальянцев, которые воспользовались услугам суррогатной ...
ср, 29/03/2017 - 08:47 — yulianna8500+210Я не понимаю причин запрета суррогатного материнства. Этика? Это должна быть проблема женщины, которая соглашается "сдать себя в аренду" за очень неплохие деньги. Никто же никого не принуждает. Знаю, в Украине и России очередь из провинциалок, которые так зарабатывают.
В двадцать первом веке не нужно будет убивать сотни граждан, дабы заполучить желанную власть над массами, достаточно лишь купить телеканалы и с их помощью воспитать будущие поколения управляемых рабов. @Дэвид Рокфеллер